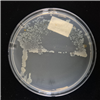

Korean Collection for Type Cultures
KCTC에서는 일반자원 분양과 특허자원 분양 서비스를 제공 합니다.
Distribution
분양
신규자원리스트
생물자원센터에 최근 새로 기탁되거나 구매하여 분양 가능한 자원 목록 입니다.
page entry
50 records /
6 pages
| 자원번호 | 학명 | 자원분류 | Biosafety Level | 산소요구성 | 분양가격 | 담기 | |
| KCTC102352 T | Emticicia paludis | Bacteria | 1 | Aerobic | 50,000 |  | |
 Type strain : Yes Other collection No. : HMF3850, CECT [9087], KCTC [42851] Only NON-COMMERCIAL USE for reference strains and/or academic researches | |||||||
| KCTC102361 T | "Flavisericum labens" | Bacteria | 2 | Aerobic | 70,000 |  | |
 Type strain : Yes Other collection No. : DST062, MCCC [1K09172] Only NON-COMMERCIAL USE for reference strains and/or academic researches | |||||||
| KCTC102430 T | Tunicatimonas pelagia | Bacteria | 1 | Aerobic | 30,000 |  | |
 Type strain : Yes Other collection No. : N5DB8-4, NBRC [107804], KCTC [23473] Only NON-COMMERCIAL USE for reference strains and/or academic researches | |||||||
| KCTC102438 T | "Maribacter luteocoastalis" | Bacteria | 2 | Aerobic | 50,000 |  | |
 Type strain : Yes Other collection No. : CXY002, MCCC [1K09937] Only NON-COMMERCIAL USE for reference strains and/or academic researches | |||||||
| KCTC102491 T | Perexilibacter aurantiacus | Bacteria | 1 | Aerobic | 50,000 |  | |
| KCTC11686 | pSGC2iN | Plasmid | 0 | Aerobic | 50,000 |  | |
 Only NON-COMMERCIAL USE for reference strains and/or academic researches | |||||||
| KCTC11687 | pSGC4iN | Plasmid | 1 | Aerobic | 50,000 |  | |
 Other collection No. : pSGC4iN, Only NON-COMMERCIAL USE for reference strains and/or academic researches | |||||||
| KCTC11688 | pSGC4iN-Pmapr | Plasmid | 1 | Aerobic | 50,000 |  | |
 Only NON-COMMERCIAL USE for reference strains and/or academic researches | |||||||
| KCTC11690 | pPICZa-AL_1 | Plasmid | 1 | Aerobic | 50,000 |  | |
 Only NON-COMMERCIAL USE for reference strains and/or academic researches | |||||||
| KCTC11691 | pPICZa-AL_2 | Plasmid | 1 | Aerobic | 50,000 |  | |
 Only NON-COMMERCIAL USE for reference strains and/or academic researches | |||||||
*저희 KCTC에서 분양받은 자원을 이용하여 논문이나 특허에 사용하실 경우, ‘본 연구에 사용된 생물자원은 KCTC로부터 제공받았음’ 문구를 반드시 기재해주시기 바랍니다.
(영문 : The biological resources used in this research were distributed from KCTC.)
 MICROBIOTA
MICROBIOTA

담당자
담당자 기탁/분양서류
기탁/분양서류 DNA분양서비스
DNA분양서비스 동결건조서비스
동결건조서비스 STR분석서비스
STR분석서비스